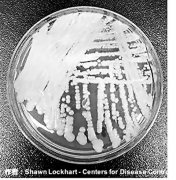

> 滚动 >
肿瘤患者应高脂肪低碳水化合物饮食
19-05-17
5月的第三周为“全民营养周”,天津市肿瘤医院开展的一项调查显示,肿瘤患者术前营养不良的发生率高达30%,常规饮食下仍有九成以上肿瘤患者蛋白质摄入...
“超级真菌”肆虐全球 到底是背谁的锅?
19-05-17
大部分抗生素都只针对细菌感染,病毒性疾病需要用抗病毒药物来治疗,而真菌感染也有相对应的抗真菌药物。事实上,抗药性在抗生素、抗病毒药物、抗真菌药物、抗寄...
不要错过孩子的语言黄金发育期 教你破译宝宝的“火星”语
19-05-17
宝宝从呱呱坠地到咿呀学语,再到能流利地与爸爸妈妈对话是一段很长也很有趣的学习过程。3-6个月的时候,宝宝听到妈妈和自己说话会咿咿呀呀地回应,在妈妈逗笑时...
90后患上帕金森病,追溯家谱意外发现父母是亲戚
19-05-16
罗巍教授告诉钱报记者,目前医学界认为5%~10%的帕金森病患者由遗传因素致病,但从他的临床经验来看,这个比例还要更高。罗巍教授的门诊来了一个90后的小伙子李青...
专家建议:孕妇要注重孕期补碘
19-05-16
” 赵建军说,根据近年的监测结果,东莞孕妇群体出现碘缺乏趋势,建议孕妇群体尤其要注重孕期补碘。赵建军说,预防措施的落实是东莞居民现时碘营养适宜的前提条...
非洲国家HIV流行率地图出炉
19-05-16
(记者张梦然)英国《自然》杂志15日在线发表一篇论文,美国科学家团队报告了2000年至2017年47个撒哈拉以南非洲国家人类免疫缺陷病毒(HIV)的流行率地图,全面...
热门观点 更多>>
- 高强度用眼人群为何纷纷选择黑目瞳作为护眼神
- 近年来,随着我国老龄化问题加剧...
- 20-07-10
- 十堰市太和医院抗衰老医学中心成立
- 衰老不可逆,但可以更优雅的衰老...
- 20-07-09
- 南召县征地800亩建设的义乌小商品批发城蒸发
- 缘何能以以政府名义立项,廉价从...
- 20-07-07
- 【杉宝解读】提高体内NAD+水平,可对抗衰老和
- 【原文标题】NAD metabolism: Im...
- 20-06-29
- i甲专线为甲状腺术后患者康复“提速” 疾病管
- 近年来,全球甲状腺癌发病率逐年...
- 20-06-15